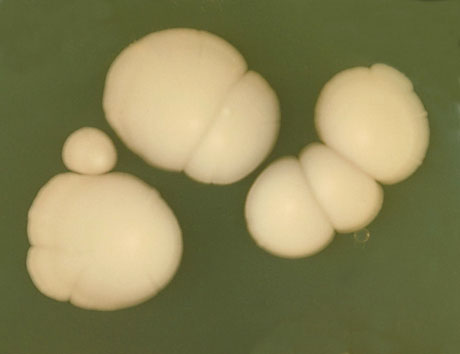
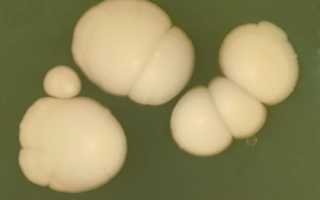

Как вылечить молочницу навсегда? Главное достоинство фитотампонов в том, что они способны устранить причину молочницы, а не только неприятные ощущения, вызванные ей.
За 2-3 курса лечебных китайских тампонов можно избавиться от молочницы навсегда. Это средство не имеет аналогов в мире, оно помогло уже тысячам женщин!
Молочница (вагинальный кандидоз) практически не знакома восточным женщинам. По статистике, в Китае лишь у 3% женщин на той или иной возрастной стадии диагностируется кандидоз, в то время, как в России этот показатель составляет более 70%, а в США и Евросоюзе, не признающих нетрадиционную медицину, и вовсе около 90%.
Фитотампоны: лечение молочницы, а не ее проявлений
Удивительные результаты дают тампоны от молочницы, избавляя женщин от недуга не просто быстро, но еще и абсолютно безопасно. Традиционные методики лечения сводятся к применению антибактериальных препаратов местного действия, пагубно влияющих на естественную среду влагалища, в результате чего его слизистая иссушается, заселяется кокковой флорой, и в разы возрастает риск развития гарднереллеза, а также возникновения иных проблем. В отличие от свечей, таблеток и мучительных, малоприятных процедур, китайские фитотампоны действуют мягко, решая первопричину недуга – дисбактериоз, а не снимая дискомфорт от его проявления.
| Причины молочницы | Эффект от фитотампонов |
| Гормональный дисбаланс | Приводят выработку половых гормонов в норму |
| Инфекция, полученная половым путем от партнера | Губительно влияют на болезнетворные микроорганизмы, не позволяя им размножаться. Служат мощной профилактикой ИППП |
| Воспалительный процесс | Снимают воспаление, заживляют раны и эрозии, нормализуют естественный баланс микрофлоры |
| Несоблюдение правил личной гигиены | Обеспечивают удаление частиц отмершего эндометрия, иных загрязнений из влагалища и полости матки, впитывают лишнюю межклеточную жидкость, слизь и выделения |
| Снижение местного иммунитета | Повышают местный иммунитет, увеличивая в разы сопротивляемость организма инфекциям |
| Стресс | Благотворно влияют на эмоциональное состояние, снимая дискомфорт, неприятные ощущения в области половых органов, делая возможной половую жизнь. Входящие в состав тампона экстракты трав обладают, среди прочего, успокаивающим действием. |
| Нарушение кровоснабжения органов малого таза | Усиливают приток крови к органам малого таза, что решает проблему застойных явлений и благотворно сказывается на женском здоровье. |
Сравнение китайских фитотампонов с методами традиционной медицины
| Критерий сравнения | Китайские тампоны | Традиционная альтернатива |
| Эффект от применения | Действуют сразу, не наносят вред | Лечебный эффект проявляется спустя несколько процедур. Вероятно нарушение состава микрофлоры |
| Вероятность рецидива болезни | Исключена | Вероятность 60% |
| Неприятные ощущения в процессе лечения | Отсутствуют | Большинство процедур (ванночки, свечи, спринцевания) неприятны, болезненны и сопряжены с изменением привычного распорядка дня |
| Возможность профилактического воздействия | Рекомендуемы как средство профилактики | Назначаются только при постановке диагноза, так как имеют места побочные эффекты и негативные последствия применения |
| Возможность интимной жизни | Рекомендуется, так как происходит одновременное лечение полового партнера | Исключена. Оба партнера лечатся отдельно |
| Китайские тампоны | Традиционная альтернатива |
| Эффект от применения | |
| Вероятность рецидива болезни | |
| Возможность профилактического воздействия | |
| Неприятные ощущения в процессе лечения | |
| Возможность интимной жизни |
Столкнувшись с диагнозом молочница, не стоит паниковать, так как, зная, чем лечить недуг, можно навсегда попрощаться с ним за считанные дни, не позволив перерасти в серьезную проблему. Фитотампоны не только незаменимы в лечении кандидоза, но и являются лучшим способом его профилактики.
Китайские тампоны от молочницы, купить курс за 960 рублей
Рекомендуемый курс лечения молочницы китайскими тампонами Clean Point — 2 упаковки (12 тампонов). В комплекте подробная инструкция на русском языке.
2 упаковки (12 тампонов) = 960 руб. Прежняя цена 1100 руб.
Грибок Кандида альбиканс (Candida albicans) под микроскопом
Кора корицы является очистительным средством при кандидозе благодаря свойству разрушать биопленку, вырабатываемую Candida Albicans для собственного сохранения. На снимке — молотая кора корицы.
Продолжаются споры, следует ли считать кандидоз болезнью или синдромом. Широкая общественность приняла его в качестве реального заболевания.
Ряд лекарственных препаратов против кандидоза убивает полезные бактерии или мешает нормальной функции гормонов. К ним относятся антибиотики, химиотерапевтические и гормональные препараты и др. Поэтому традиционная китайская медицина (ТКМ) использует свои методы.
Лечение
Приведенная ниже информация предназначена исключительно для ознакомления. Прежде чем обращаться к ТКМ, необходимо посоветоваться со своим лечащим врачом о целесообразности этого.
Кандидоз методами ТКМ лечится в два этапа.
Исследования показывают, что акупунктура / акупрессура тоже эффективна для очистки от дрожжевых инфекций. Некоторые обычно используемые для этого точки: LIV3, LIV2, ST40, UB57 и LI4.
При проведении сеансов акупунктуры / акупрессуры для тонизации воздействуют на точки ST36, SP9, SP6, LI10, LIV8, REN6 и REN4.
Что касается лечебных диет при кандидозе, то четких доказательств их эффективности нет. Такими доказательствами должны быть клинические испытания с зафиксированными результатами. В то же время, сообщалось об интересной связи между более высоким уровнем грибка и потреблением углеводов. Поэтому нередко врачи рекомендуют снижать потребление сладкого, мучного, некоторых молочных продуктов и т. д.
Ключом к долгосрочному контролю над избыточным ростом кандид является продвижение нормальной здоровой флоры и фауны в кишечнике. Если диета решит эту задачу на долгое время вперед, значит она составлена правильно. Если диета только снимает симптомы на короткое время и не решает кардинально ситуацию в кишечнике, значит она практически бесполезная.
Опасный грибок Кандида аурис
Основные проблемы заключаются в том, что Candida auris трудно быстро отличить от других типов кандид, а также, что он приобрел устойчивость к противогрибковым лекарствам. Почти одновременное появление на разных континентах грибка с высокой лекарственной устойчивостью, действующего как бактерия, вызывает тревогу. Некоторые ученые допускают, что Кандида аурис защищается от лекарств тоже с помощью биопленки как и Кандида альбиканс, но еще более эффективно.
Факторы риска заболеть следующие.
- сахарный диабет
- длительное применение и / или частая смена антибиотиков
- анорексия
- длительное применение больших доз гормонов (глюкокортикоидов).
В настоящее время делаются попытки разработать препараты против Кандида аурис. Не исключено, что и китайская фитотерапия найдет здесь свое место.
Редакция сайта не проверяет достоверность информации в отзывах и комментариях. Будьте внимательны при ее оценке.
В начале находятся более старые комментарии, а более новые — в нижней части.
Китайская медицина иглоукалывания основана на эффекте Плацебо и не более.
Плацебо может присутствовать в любом методе лечения. Однако иглоукалывание или точечный массаж основаны на научных фактах. Так, известно, что там, где находятся биологически активные точки, очень много нервных клеток и капилляров. Воздействие на них помогает запусить внутренние процессы регуляции организма без серьезного вмешательства. Я, например, поднимал и понижал давление много раз при помощи точечного массажа. И речь не шла о самовнушении, потому что те, кому я помогал, не особо верили в этот метод.
Владислав, вы изучали китайскую медицину? Нет. Вы знаок западной медицины — скорее всего тоже нет. Так не делайте выводы в том, о чёмне имеете представления даже.
Организму надо помогать набирать энергию по потребности и тратить по возможности соблюдая ее баланс
Кандиды принадлежат к дрожжеподобным грибам, и они – не единственные постоянные обитатели человеческой микрофлоры. Эпизоды их неуемного роста происходят часто потому, что их провоцирует масса различных факторов. Препараты от молочницы представлены как местными, так и системными средствами. Представляем вашему вниманию рейтинг лучших разработок для взрослых и ребенка.
Препараты против молочницы: какие бывают?
Разнообразие недорогих и эффективных средств против грибка касается скорее названий, чем действующих элементов. Их общий список делят на:
- фунгициды – убивающие патоген;
- фунгистатики – прекращающие его размножение.
Плюс, они различаются по составу (моно- или комбинированные), степени токсичности и для человека (не только грибка-паразита), длине списка и частоте побочных эффектов. По способу применения антимикотики бывают общими и местными. У каждого из них есть свои преимущества и недостатки. Кандиды имеются у всех обитателей Земли. В норме они служат для поддержания:
- стабильности бактериально-грибкового соотношения;
- кислого баланса среды вокруг.
Избавляться от них на все 100% не нужно. Повторное заражение все равно произойдет очень скоро, да и вреда свобода от них принесет больше, чем пользы. Фунгициды же нацелены именно на тотальное уничтожение кандидоза. С другой стороны, фунгистатики демонстрируют низкий результат, когда колония смешанная или устойчивая к терапии, собственный иммунитет близок к отказу.
На что обращать внимание?
Выбирать недорогие противогрибковые препараты нужно, исходя из текущего состояния здоровья пациента. Обычно о нем можно судить по тяжести рецидивов всех хронических патологий, включая кандидоз.
После курса иммунодепрессантов, операции, травм, родов часто хватает и местной терапии фунгистатиками. А при СПИДе, после лучевой и химиотерапии, обладателям донорских органов (иммуносупрессоры до конца жизни) обычно требуется общее лечение, часто – фунгицидами.
Дополнительно стоит учитывать, что противогрибковые соединения действуют узко на дрожжеподобную часть микрофлоры. А вот наиболее действенные против нее недорогие антибиотики затрагивают и остальные компоненты, могут усилить уже существующий дисбаланс.
Препараты от кандидоза. ТОП-10 недорогих и эффективных
Данное средство уникально в своем роде, так как появилось оно в результате научной проверки противогрибковых свойств растений, открытых народной медициной. Состав Кандистона полностью натурален, но его рецептура и пропорции разработаны с учетом самых современных знаний и технологий.
- каприловая кислота – которой сильнее всего насыщено кокосовое масло. В животных жирах она высвобождается по мере прогоркания. Каприловая кислота является натуральным антисептиком;
- алоэ-эмодин – противоопухолевый и гепатопротекторный компонент сока алоэ, повышающий чувствительность клеток к сахару у диабетиков. Он также обладает свойствами антимикотика;
- тимол – аромакомпонент масла чабреца, придающий ему острый привкус и сильный узнаваемый аромат. Тимол эффективен против глистов, грибов, микробов, используется для местного обеззараживания в официальной медицине;
- сапонины алоэ – придающие соку растения тягучую липковатую текстуру. Сапонины являются основой натурального мыла, и их прием внутрь не дает ничего, кроме диареи (если нужно почистить кишечник) с острыми спазмами. Ими сильно насыщена лебеда. Но при внешнем нанесении они представляют собой крайне неблагоприятную для выживания патогенов среду;
- инулин – компонент растительного сахара фруктозы, питательная добавка для полезных молочнокислых бактерий, контролирующих рост грибка.
Недорогой препарат для лечения кандидоза Кандистон одинаково подходит для мужчин, женщин и детей, поскольку является натуральным гипоаллергенным спреем. Его наносят на вымытую просто водой кожу половых (или любых других пораженных) органов с помощью пульверизатора на флаконе, трижды в сутки, неделю. Терапию Кандистоном, как и любым средством от урогенитальной инфекции, нужно сразу рассчитывать для двоих партнеров.
На протяжении курса следует носить не тесное белье из натуральных тканей. Для России стоимость флакона Кандистона на 30 мл составляет 990 р. Для Украины – 469 грн. Во избежание подделок и переплат покупать его следует исключительно на официальном сайте производителя. Ознакомиться с подробным описанием и отзывами о спрее Кандистон вы можете на соответствующей странице.
В силу особенностей анатомии, прекрасному полу чаще сильного приходится использовать одновременно 2-3 лекарственные формы одного препарата для избавления от кандидоза. Обычно речь идет о смазывании вульвы и кожи, а также введении свеч для стенок влагалища. При такой схеме приема важно следить за суточной дозировкой действующих компонентов.
Основу лекарства Бетадин образует связанный абсорбентом поливинилпирролидоном (сокращенно – повидоном) йод. Их сочетание позволяет йоду сохранить свои антимикробные свойства при уменьшении обжигающего действия. Этот относительно новый вид антисептика производится в:
- свечах – 200 мг;
- растворе (смазывание) – 10%;
- креме – 10%.
Женщинам показаны свечи (по 1 шт. на ночь, 14 суток) и/или раствор (по мере надобности). Полный курс суппозиториев обойдется примерно в 515 руб., а 30 мл раствора – в 161-175 рублей. Препараты от молочницы у женщин такого типа продаются без рецепта.
Действующее вещество от кандидоза в нем такое же, как указано в его названии. Азолов сейчас насчитывается больше десятка. Они крайне эффективны в борьбе с кандидами, но и токсичны на печень (у грибка они разрушают тот же фермент, что используют гепатоциты). Самое разумное – применять их локально и ограниченными во времени курсами. Клотримазол с флуконазолом (образует основу Флюкостата) в их списке – самые нейтральные в этом плане. Клотримазол выпускается в:
- суппозиториях – по 100 мг;
- в таблетках (тоже вагинальных) – аналогичная концентрация;
- мази – 2%;
- крема – 1%;
- раствора (наружно и при кандидозе во рту) – 1%;
- порошка (присыпка для кожи) – 1%.
Интравагинально и на очагах роста псевдогрибницы его применяют утром и вечером (допустимо до 3 раз за сутки), не дольше 14 дней. Стоит Клотримазол дешево – 12-50 руб. за 6 шт., хотя крем обойдется дороже (из-за импортного происхождения) – 145-160 р.
Основа Залаина сертаконазол принадлежит к тому же ряду производных имидазола. Он чуть менее безопасен, зато обладает расширенным спектром действия и является крайне эффективным. Тоже имеет исключительно внешнее употребление:
- неомицина – 35 тыс. МЕ;
- полимиксина В – в такой же дозировке;
- нистатина – сто тыс. ЕД.
Обеспечивающие полноценное лечение молочницы у женщин препараты на смешанной основе представлены Тержинаном. Он тоже имеет лишь одну разновидность вагинальных таблеток с:
- тернидазолом (один ряд с сертако- и клотримазолом) – 200 миллиграммов;
- неомицином – 65 000 МЕ;
- нистатином – 100 000 ЕД;
- преднизолоном (стероид) – 3 мг.
Тержинан для женщин вводят поглубже по одной таблетке в сутки, предварительно подержав ее несколько секунд в воде, лечатся курсами до 20 суток. Шесть штук покупают за 410-470 р., десяток – за 540-590 р.
Фентиконазол в качестве действующей части Ломексина выпускается в:
- вагинальных капсулах (для женщин) – по 600-1000 миллиграммов;
- мази (для мужчин) – двухпроцентной.
Препараты для лечения молочницы у мужчин с фентиконазолом эффективны в отношении одних трихомонад и кандид. Ломексин наносят дважды в день, на все очаги воспалений, до исчезновения симптомов плюс еще 3 суток. Приобрести Ломексин для мужчин можно за 470-560 рублей.
- крем – двухпроцентный;
- шампунь – аналогично.
До 2014 г под названием Низорала выпускались и пероральные пилюли по 200 миллиграммов. Но сейчас с кетоконазолом в этой форме можно купить только Микозорал. Таблетки с ним назначают раз в сутки, по 400 миллиграммов, сроком до 14 суток, под постоянным наблюдением за уровнем печеночных трансаминаз. Крем наносят до 3 раз за день, пока не исчезнут симптомы молочницы плюс еще 3-4 сут.
Перечисленные выше препараты от кандидоза в большинстве пригодны к применению у детей. Разница в том, что азольные производные назначаются у детей, только если нет альтернативы. Однозначно показаны для детей недорогие препараты от молочницы натурального происхождения, как спрей Кандистон.
Подобно остальным, Пимафуцин удобен для детей, взрослых женщин и мужчин, включает таблетки для общего приема. Он основан на макролиде натамицине:
Полностью синтетические макролиды считаются одними из самых безопасных с точки зрения побочных действий. А Пимафуцин – едва ли не лучший препарат от молочницы из недорогих, показанный детям до годика.
Для детей от полугода доза внутрь составляет сотню миллиграммов дважды в сутки, неделю, в промежутках между приемами пищи. Наружно – до 4 раз за день, сроком до месяца, пока полностью не пройдет кандидоз. Считается, что его передозировка у детей и взрослых крайне маловероятна. Купить его можно за 310-350 р. (крем) и 490-560 руб. (таб.).
- ректальных и вагинальных свечах – по 250/500 тыс. МЕ;
- мази – по 100 тысяч;
- таб. – с 500 000 единиц действия.
Для детей в приведенном списке подходит все, кроме суппозиториев (не исключены, просто менее желательны). Для смазывания Нистатин используют без ограничений, внутрь – начиная с первого полугодия жизни, в суточной дозировке:
- до года – не больше 125 тыс. ед.;
- 1-3 г. – 250 000 международных единиц;
- далее – миллион или полтора единиц в сутки.
Число приемов может колебаться от 2 до 5, но препарат дают только после еды. Срок лечения составляет до 2 недель. Наружные виды нистатина стоят 40-75 рублей (15 или 30 г), сотню капсул покупают, в среднем, за 132 р.
Противопоказания и побочные эффекты
- не применяется при проблемах желчного пузыря и сердца:
- усиливает действие почти всех принимаемых совместно лекарств, от снотворных и анальгетиков до антигистаминных;
- требует отказа от спиртного.
Антибиотики, кроме Пимафуцина, исключены у женщин на время беременности и грудного вскармливания. Бетадин эффективен, но запрещен при любых аутоиммунных заболеваниях, почечной недостаточности, гипертиреозе, нейтропении (повышенные нейтрофилы крови). Нистатин, помимо прочего, нельзя глотать при язве желудка/кишечника, панкреатите. И ни одно лекарство нельзя употреблять при непереносимости его действующего или вспомогательных веществ.
Отзывы
Элеонора, 26 лет:
Любомир, 32 года:
Ангелина, 40 лет:
Лекарства от простудных заболеваний и гриппа:
- 快克 — Paracetamol and Amantadine) Цена ≈ 14.80 юаней
- 日夜百服宁 — Bufferin Cold — (в сост. Paracetamol, Dextromethorphan и другие активные вещества.) Цена ≈ 9.80-13.20 юаней
- 泰诺酚麻美敏片 — Tylenol Cold (Paracetamol, Dextromethorphan и другие активные вещества) Цена ≈ 15 юаней
- 三精双黄连口服液 — эффективный горько- сладкий сироп от симптомов простуды. Цена ≈11-15 юаней
- 999 Gan Mao Ling (999感冒灵) — порошок для профилактики и лечения гриппа и простуды. Цена ≈ 10 юаней
- 四季感冒片 — лекарство от простуды и гриппа, устраняет слабость организма Цена ≈ 5-20 юаней
От кашля:
- 枇杷膏 Pipa Gao — Сироп от кашля и першения в горле. Цена 20-30 юаней
- 桂林西瓜霜 анальгетик, устраняет воспаления, жар Цена от 5-10 юаней
- 清开灵片 (颗粒) — таблетки при простуде, жаре, кашле и больном горле
- 止咳丸 – гомеопатия от кашля. При применении с сиропом от кашля, эффект улучшается Цена 18.00
- 痰咳浄片 от мокрот, кашель,одышка, астма.. При бронхитах, фарингитах.
От насморка:
- 鼻腔喷雾器 спрей для носа
- 小柴胡颗粒 — аналог ингавирин, кагоцел
- 芥未粉( 芥未药粉) – горчичный порошок
盐酸洛美沙星滴耳液, 盐酸左氧氟沙星滴耳液капли при воспалении воспаление среднего уха, наружном отите Цена 13.60
От головной боли:
- 阿咖酚散 (или 头疼粉 tóuténg fěn) аналог цитрамона , в виде белого порошка в пакетиках
- 必理通 – панадол Цена ≈6-10 юаней
- 霍香正气口服液 — против 中暑 — теплового удара. На вкус противненькая, но помогает. Можно для профилактики пить.
Лечение и уход за кожей:
- 云南白药 — от ушиб и ран, рассеивание застоя крови и активизирование кровообращения. Цена ≈ 30.00 麝香祛痛搽剂 – мазь от синяков с согревающим эффекто. Цена ≈ 49 юней
- 美宝湿润烧伤膏 — мазь от ожогов Цена≈ ¥34
- 莫匹罗星软膏 — мупироцин, мазь-антисептик, не антибиотик,не возникает резистентности, к примеру, может остановить зреющий фурункул. Цена≈13.70-26.8
- 芦荟软胶囊 — софт-гель капсулы с алоэ верой. Мягко очищает кожу. Цена от 60 юаней 海娜粉 — Хна. Есть цветная и бесцветная,полезно для волос.
- 红霉素软膏 — Мазь Эритромицин (угревая сыпь, прыщи, гнойничковые образования на коже, ожоги различной степени тяжести, пролежни, трофические язвы) . Цена от 5 юаней
- 牛黄消炎片 — жаропонижающий препарат, устраняет воспаления, обезболивает, используется при фурункулах, воспалениях ран Цена ¥6.60 — 12.00
- 莫匹罗星 — антибиотик для наружного применения при заражении кожи. Цена ¥13.70-26.80
- 夏枯草膏 — устранение воспаления, при мастите, воспалении щитовидной железы Цена ¥23.80-23.90
- 红霉素软膏 — эритромициновая мазь при гнойных кожный заболеваниях и заражениях кожи, язве, ожогах малой поверхности кожи
- 林可霉素利多卡因凝胶 — мазь, используется при легких ожогах, ранах и укусах насекомых Цена ¥7
- 复方酮康唑软膏 — мазь при грибковых заболеваниях кожи. Цена ¥ 5.90-12.30
- 999曲安奈德益康唑软膏 — мазь при экземе и микозе Цена ¥ 15-17
- 999复方醋酸地塞米松软膏, 999抗酸莫米松凝胶 — мазь для лечения дерматитов, экземы и аллергии , при нейродермите, контактном дерматите, себорейной и хронической экземе Цена ¥ 8
- 999曲安奈德益康唑软膏 — мазь при паронихие(воспалении околоногтевого валика) Цена ¥ 13.70-27.50
- 独癣 — чесотка, экзема, лишай, плесневой микоз ног, дерматит, аллергия, укусы насекомых, псориаз
- 醋康他索乳膏 — мазь при дерматите и экземе
- 曲咪新软膏 — мазь при экземе, дерматите, вызванном механическими раздражителями, при себорейном дерматите, невродермите, лишае
- 换肤草 — мазь от укусов насекомых, зуда, лишая и герпеса
- 皮肤病血毒丸 — китайское лекарство от воспаления на коже Цена 8.50-9.00
- 肉豆蔻酰胺 — мирамистин
- 地球人抑菌乳膏 ,梦之效抑菌乳膏 — мазь для лечения всех видов аллергии, экземы, псориаза, трещинок на коже, дерматитов, дерматофии кистей и стоп)
Грибок на ногах:
- 999硝酸咪康唑乳膏,复方醋康唑软膏,丫丫爽 – противогрибковое средство Цена 11.90-15.00 юаней
- 盐酸特比萘芬喷雾 — противогрибковый спрей Цена 11.80-23.50 юаней
- 脚护士泡足片 — шипучие таблетки от дурного запаха и потливости стоп (по причине грибка)
- 脚清爽 , 冰王脚爽净 — спрей от потливости ног
- 京万红软膏, 湿润烧伤膏, 烧烫伤软膏 — мазь при ожоге кожи Цена 4.50-16.00 юаней
От выпадение волос:
- 101В防脱育发剂 — лосьон
- 101防脱洗发精 — шампунь от выпадения волос
- 101养发香波 — шампунь для выращивания волос
Базовые средства:
- 创可贴 — лейкопластырь
- 喷雾剂 — спрей, распылитель, пульверизатор
- 棉花 — вата
- 绷带 — бинт
- 弹性绷带 — эластичный бинт
- 消毒棉球 — ватные шарики с йодом (для мелких ран)
- 碘伏 — йод на основе воды(менее раздражает кожу, для повседневного применения)
- 碘酒 — йод на спиртовой основе(используется при операциях)
- 缬草属, 昆仑雪菊 — валериана
- 高锰酸钾 — марганцовка
- 消毒液 — дезинфицирующий раствор
- 消毒酒精 — раствор алкоголя для дезинфекции
- 过氧化氢, 双氧水 — перекись водорода
- 隐形眼镜 — контактные линзы
- 隐形眼镜护理液 — раствор для хранения контактных линз
Разное:
- 复方门冬维甘滴眼液 — капли от усталости глаз, смягчает конъюктивальную гиперемию Цена 14.90-15.00 юаней
- 美拉托宁 — мелатонин (для сна). Продаётся на Таобао, только из США. Некоторые продавцы доставляют прям из США, для оплаты требуется китайский 身份证, т.к. конвертация валюты. Но некоторые продают уже из Китая, проще через них.
- 氯雷他定 — лорантадин, антигистаминный, от аллергии. Цена 9.90-14.50 юаней
- 左旋肉碱 — Л-карнитин — входит в состав таблеток для похудения, на таобао можно найти чистый порошок и импортные таблетки чистого л-карнитина. Применяется за 30 мин дотренировки — увеличивает выносливость и ускоряет метаболизм, потоотделение.
- 去氧孕烯炔雌醇片, 炔雌醇环丙孕酮片 — противозачаточное таблетки
- 脑心舒口服液 — седативное, мягкое. Сироп на травах успокаивающий ,устраняет беспокойство и нормализирует сон, в ампулах. Цена 15.00
- 犹将军 — аналог кондилина. От кондилом.
- 重组人干扰素a-2b抑菌软膏 Гель с интерфероном рекомбинантным человеческим, от тех же кондилом. Но эти средства кажется лучше покупать в России. В геле например концентрация ниже чем в мази
- 盐酸特比萘芬 — гидрохлорид тербинафина (в виде спрея), антигрибковое
- 灭菌结晶磺胺 — стрептоцид (противомикробное)
- 氯己定 — антисептик , хлоргексидин (суть мирамистин). В аптеках продается много средств (лосьонов для интимной гигиены) с хлоргексидином. Но также есть просто лосьоны на травках, поэтому читайте состав.
- 阿苯达唑片 — (альбендазол) китайские проверенные средства от глистов и прочих паразитов
- 夏枯草膏 — сироп убирает воспаление щитовидки и уменьшает зоб. Также убирает опухоли, например вместе с乳癖消片рассасывает опухоли молочной железы (любые маститы и мастопатии), загрубение молочных желез. Также этот сироп можно использовать при воспалении лимфатических узлов вместе с каким-нибудь антибиотиком, например с 罗红霉素片 (рокситромицин)
- 消银片 — таблетки от псориаза
- 独癣请 — мазь от псориаза
- 天麻丸 — лекарство при ревматических болях и болях в суставах Цена 19.50-25.60
- 附桂骨痛胶囊 — если суставы опухают, но боли не ревматического характера, а именно кости болят, снимает опухоль и воспаление, озноб в конечностях Цена 25-35 юаней
- 小活络丸 — препарат для активизации кровообращения для утоления боли,при криалгезии,дискомфорте при сгибании суставов,онемении
- 青鹏软膏 — мазь от артритной боли, подагры, Цена 19.20-26.00 юаней
- 双氧芬酸钠缓释胶囊 , 双氧芬酸钠肠溶片 — обезболивающие таблетки на основе диклофенака для устранения артритной боли
- 姊妹舒 — лечебные прокладки при воспаления органов малого таза (бактериальные, вирусные, грибковые), нарушения менструального цикла (аменорея, альгодисаменорея, олиго- и полименорея, предменструальный синдром), цистит, молочница, зуд наружных половых органов, послеоперационный период после аборта и родов, эндометриоз, эрозия и псевдоэрозия шейки матки, эндокринные нарушения половой сферы.
При эрозии
- 消糜栓 — свечи. Показания: трихомонадный вагинит, грибковый кольпит. Цена 32.70 юаней
- 清宫丸 — лечебные тампоны (показания: миома матки, эрозия, вагинит, гонорея, молочница, опухоль яичников, эндометрит, нерегулярные месячные)
При молочнице:
- свечи 达克宁+спринцевание 洁尔阴洗液
- 艾阴洁(+妇科白带膏 в запущенных случаях)
- 清宫丸 — лечебные тампоны
Болючие месячные, опаздывающие месячные:
- 妇科调经颗粒 — (если месячные обильные, то принимать не стоит, т.к. препарат 养血)
- Мастопатия: 乳癖消片+夏枯草膏 курсом
- 桂枝茯苓胶囊 — киста яичников, миома матки, эндометриоз, а также мастопатия Цена 32.50-65.00
- 调经促孕丸 — лекарство для стабилизации менструального цикла, Показания при скудной менструации, бесплодии Цена 15.10 юаней
- 腺激酶 — хронический простатит, воспаление, аденома, импотенция, гипертрофия предстательной железы
- 姊妹舒 — Лечебные прокладки при остром и хроническом простатите
- 盐酸左氧氟沙星片 — таблетки при заражении мочеполовой системы. Цена 3.54-11.00
Больница
- 挂号 — При посещении китайской больницы первым делом следует зарегистрироваться и создать карточку при первом посещении
- 医院 - больница
- 医院在哪里? — где больница?
- 检查 — осмотр
- 手术 — операция
- 诊所 — клиника
- 注射 — инъекция, укол
- 挂号 — получить номер приема в больнице
- 挂个内科 - дайте номерок к терапевту
- 内科 — терапевтическое отделение
- 外科 — хирургическое отделение
- 妇科 — гинекологическое отделение
- 儿科 — детское отделение
- 眼科 — офтальмология
- 皮肤科 — дерматологическое отделение
- 耳鼻喉科 — отоларингология
- 口腔科 — отделение стоматологии
- 中医科 — отделение китайской (традиционной) медицины
- 心理咨询 — психологическая консультация
- 针灸推拿 — отдел акупунктуры и массажа
- 肿瘤科 — онкологическое отделение
- 挂号处 — регистратура
- 病历卡 — медицинская карта
- 抽血 — пускать кровь
- 配药 — покупать лекарство по рецепту
Дантист — 牙医
- 补牙 — ставить пломбу
- 齿冠 — ставить коронку
- 臼齿 — коренные зубы
- 门牙 — резцы
- 犬齿 — резцы
- 神经 — нерв
- 牙痛 — зубная боль
- 釉 — эмаль
Беременность — 怀孕
- 早孕试纸 — бумажный тест на беременность
- 测孕 — тест на беременность
- 早期妊娠 — ранний срок беременности (中期、晚期)
- 胎体、胎 — плод
- 分娩 — разрешение от плода
- 婴儿 — младенец
- 子宫 — матка
- 口服 - пероральный приём лекарства
- 开水冲服 — растворить в кипяченой воде
- 一次1袋,一日3次 — за 1 раз (次) — 1 пакетик, за 1 день (日) 3 раза
- 创可贴 — лейкопластырь
- 喷雾剂 — спрей, распылитель, пульверизатор
- 棉花 — вата
- 绷带 — бинт
- 弹性绷带 — эластичный бинт
- 消毒棉球 — ватные шарики с йодом (для мелких ран)
- 碘伏 — йод на основе воды(менее раздражает кожу, для повседневного применения)
- 碘酒 — йод на спиртовой основе(используется при операциях)
- 缬草属, 昆仑雪菊 — валериана
- 高锰酸钾 — марганцовка
- 消毒液 — дезинфицирующий раствор
- 消毒酒精 — раствор алкоголя для дезинфекции
- 过氧化氢, 双氧水 — перекись водорода
- 隐形眼镜 — контактные линзы
- 隐形眼镜护理液 — раствор для хранения контактных линз
в Китае может возникнуть необходимость покупки медицинских препаратов через аптечную сеть. Данный список поможет Вам в этом.
Сегодня Мы должны сделать все, чтобы завтра стать лучше!
Читайте также: